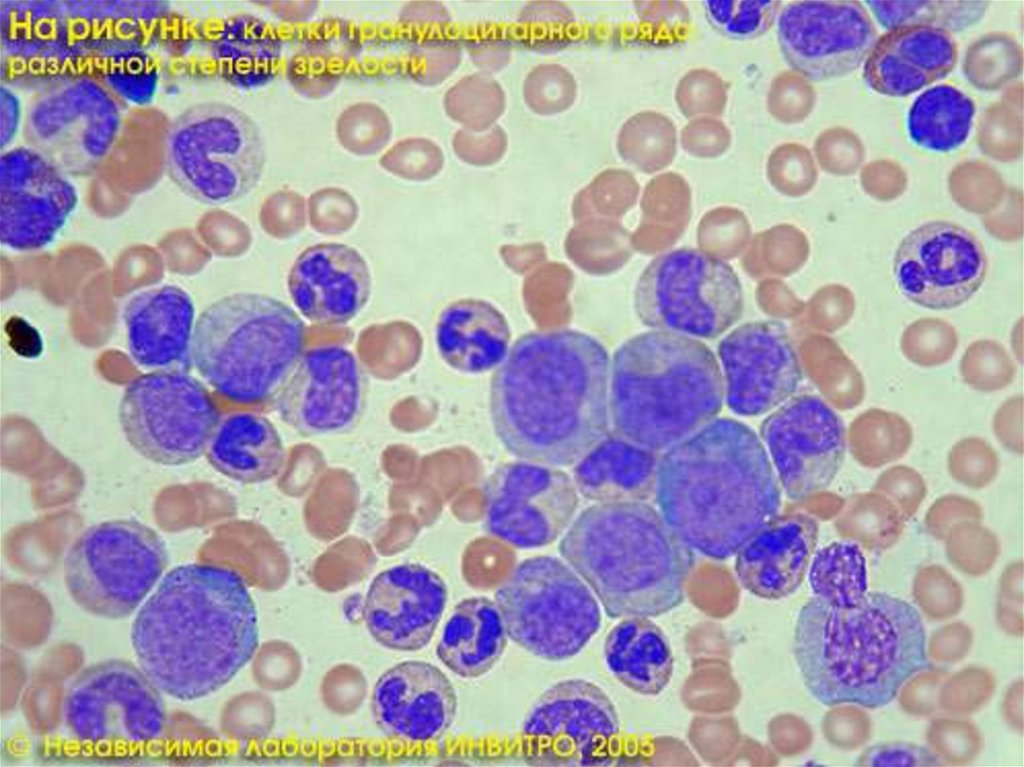

Similar presentations:
Анатомия животных
1. Лабораторная работа 1-2
2. Анатомия животных – раздел морфологии, изучающий развитие и строение организма животных в связи с функцией, воздействием
окружающей среды инаследственными факторам.
3.
4.
Задачи анатомии:Выявить закономерности строения животного
Использовать эти закономерности в
технологиях производства животноводства.
Изучить коррелятивное влияние
изменяющегося органа на другие органы.
Изучить влияние внешних факторов на
формообразование.
Значение анатомии:
Общеобразовательное
Прикладное
5.
БиологияМорфология
Физиология
Анатомия
макроскопическая
микроскопическая
макро- микроскопическая
Топографическая
(хирургическая,
регионарная)
Нормальная
(описательная),
системная
Сравнительная
(эволюционная)
цитология
гистология
Возрастная,
породная
экологическая
клиническая
функциональная
6.
ОБЪЕКТЫ ИЗУЧЕНИЯ АНАТОМИИ ЖИВОТНЫХптицы
млекопитающие
копытные
хищные
лошадь
собака
свинья
кошка
жвачные
пушные
звери
крупный рогатый
скот,
мелкий рогатый
скот,
олени
норка,
соболь,
лисица,
песец
мозоленогие
верблюд
зайцеоб
разные
кролик
куриные
куры.
индейки,
цесарки
гусеобразные
Гуси,
утки
7.
Методология анатомииАНАЛИЗ – метод дедукции: от
сложного к простому, от
общего через единичное к
частному
СИНТЕЗ – метод индукции:
от простого к сложному, от
частного через единичное
к общему
8. Методы изучения анатомии:
I группарассечения, или препарирования;
вымачивания трупов;
распилов замороженных трупов;
наливки или инъекции (заполнения) органов;
коррозии или разъедания;
макро- микроскопический.
электронной микроскопии
II группа
рентгенологический и его модификации (рентгеноскопия,
рентгенография, рентгенокимография);
соматоскопический;
соматометрический, или антропометрический;
эндоскопии внутренних органов;
радиоизотопный;
ультразвуковой эхолокации с доплерографией;
парамагнитного резонанса.
9.
10.
11.
12.
13.
Копьютерная томография14.
Мультиспиральная компьютернаятомография
15.
Ультразвуковая диагностика16.
Магнитно-резонанснаятомография мозга. Снимок
здорового мозга (А);
изменения мозгового
вещества при болезни
Бинсвангера — разрежения
белого вещества мозга (Б);
гидроцефалия —
накопление жидкости в
мозговых тканях —
проявляется в виде
расширения борозд и
желудочков мозга (показаны
стрелками) (В);
мультиинфарктное
состояние — омертвевшая
нервная ткань выглядит как
небольшие темные пятна
(показаны стрелками) (Г).
Изображение: «Наука и
жизнь»
17.
Уровни организации организмаорганизм
Система органов и аппараты
орган
ткань
Функциональный элемент органа
клетка
органеллы
18. Организм - целостная биотканевая динамичная система, имеющая иерархическое строение, элементы которой функционируют как единое
целое19.
20. Система – совокупность органов, имеющих общее происхождение, тесную морфологическую взаимозависимость и выполняющих строго
определенную функцию.21.
22. Аппарат - совокупность органов, которые не смотря на различие в своем строении, топографии и происхождении, объединены между
собой для обеспечениякакого-либо определенного
жизненно важного процесса в
организме.
23.
24. Орган – ориентированный в пространстве структурно-тканевой комплекс, имеющий специфику строения и функционирования. Орган
Орган – ориентированный впространстве структурнотканевой комплекс, имеющий
специфику строения и
функционирования. Орган
состоит из нескольких тканей,
одна из которых доминирует и
определяет его
функциональное значение.
25. Различают следующие виды органов: * паренхиматозные (почки, печень) для них характерна строма и паренхима), * трубкообразные
органы (пищевод, трахея),* рудиментарные, провизорные (переменные),
* атавистические, дифинтивные (постоянные),
* аналогичные, гомологичные, гомотипичные
(органы, занимающие одно положение, и
симметрично похожие друг на друга),
* гомодинамные (органы, построенные по
определённому плану: позвонки, грудная и
свободная тазовая конечность.
26. Признаки органа: 1. форма. 2. Строение. 3. Происхождение (развитие). 4. Функции. 5. Положение в организме (топография).
27. Органы объединены в три группы:
1. Группа соматическая:- скелет (кости и их соединения)
- мускулатура (скелетная)
- кожный покров и его производные.
аппарат движения
(опорно-двигательный
аппарат)
2. Группа висцеральная (спланхническая):
- пищеварительный аппарат;
- дыхательный аппарат;
- мочеполовой аппарат: органы выделения и размножения.
3. Интегрирующая группа:
- сердечнососудистая система
- эндокринный аппарат
- нервная система
- органы чувств
группа сосудистогуморальной связи
группа нервной интеграции
деятельности и связи с
внешней средой
28.
29. Ткань – совокупность более менее однородных клеток и их производных, объединённых общностью строения, функций и происхождения.
30. Эпителиальная
Плоский эпителий. Поверхность клеток гладкая. Клеткиплотно примыкают друг к другу (поверхность кожи, ротовая
полость, пищевод, альвеолы, капсулы нефронов)
Функция: Покровная, защитная, выделительная (газообмен,
выделение мочи)
Железистый эпителий. Железистые клетки вырабатывают
секрет (железы кожи, желудок, кишечник, железы внутренней
секреции, слюнные железы)
Функция: Выделительная (выделение пота, слез), секреторная
(образование слюны, желудочного и кишечного сока, гормонов)
Мерцательный (реснитчатый) эпителий. Состоит из клеток с
многочисленными волосками(реснички) (дыхательные пути)
Функция: Защитная (реснички задерживают и удаляют частицы
пыли)
31.
12
3
4
5
Эпителиальная ткань
1 – плоский; 2 – кубический; 3 – цилиндрический; 4 - многорядный эпителий; 5 – многослойный плоский эпителий
32.
Многослойный эпителий33.
Переходный эпителий мочевогопузыря собаки в растянутом виде
Переходный эпителий мочевого пузыря
собаки в состоянии покоя
34. Соединительная
Плотная волокнистая Группы волокнистых, плотно лежащих клеток без межклеточноговещества (собственно кожа, сухожилия, связки, оболочки кровеносных сосудов, роговица
глаза)
Функция: Покровная, защитная, двигательная
Рыхлая волокнистая Рыхло расположенные волокнистые клетки, переплетающиеся
между собой. Межклеточное вещество бесструктурное (подкожная жировая клетчатка,
околосердечная сумка, проводящие пути нервной системы)
Функция: Соединяет кожу с мышцами, поддерживает органы в организме, заполняет
промежутки между органами. Осуществляет терморегуляцию тела
Хрящевая Живые круглые или овальные клетки, лежащие в капсулах, межклеточное
вещество плотное, упругое, прозрачное (межпозвоночные диски, хрящи гортани, трахеи,
ушная раковина, поверхность суставов)
Функция: Сглаживание трущихся поверхностей костей. Защита от деформации дыхательных
путей, ушных раковин
Костная Живые клетки с длинными отростками, соединенные между собой, межклеточное
вещество – неорганические соли и белок оссеин (кости скелета)
Функция: Опорная, двигательная, защитная
Кровь и лимфа Жидкая соединительная ткань, состоит из форменных элементов
(клеток) и плазмы (жидкость с растворенными в ней органическими и минеральными
веществами – сыворотка и белок фибриноген) (кровеносная система всего организма)
Функция: Разносит О2 и питательные вещества по всему организму. Собирает СО2 и продукты
диссимиляции. Обеспечивает постоянство внутренней среды, химический и газовый состав
организма. Защитная (иммунитет). Регуляторная (гуморальная)
35.
Плотнаяволокнистая
соединительная
ткань сетчатого
слоя кожи
36.
Рыхлая волокнистая ткань37.
12
Хрящевые ткани:
1 – гиалиновый хрящ; 2 – эластичный хрящ; 3 - волокнистый хрящ
3
38.
Костная ткань39.
40.
41. Мышечная
Поперечно–полосатая Многоядерные клеткицилиндрической формы до 10 см длины, исчерченные
поперечными полосами (скелетные мышцы, сердечная мышца)
Функция: Произвольные движения тела и его частей, мимика лица,
речь. Непроизвольные сокращения (автоматия) сердечной
мышцы для проталкивания крови через камеры сердца. Имеет
свойства возбудимости и сократимости
Гладкая Одноядерные клетки до 0,5 мм длины с заостренными
концами (стенки пищеварительного тракта, кровеносных и
лимфатических сосудов, мышцы кожи)
Функция: Непроизвольные сокращения стенок внутренних полых
органов. Поднятие волос на коже
42.
12
3
Рис. Мышечные ткани:
1 – скелетная поперечнополосатая; 2 – гладкая; 3 – сердечная поперечнополосатая
43.
Скелетные мышцыСердечная мышца
Гладкая мышечная
ткань
44. Нервная
Нервные клетки (нейроны) Тела нервных клеток, разнообразные поКороткие отростки нейронов – древовидноветвящиеся
дендриты Соединяются с отростками соседних клеток Передают
форме и величине, до 0,1 мм в диаметре Образуют серое вещество
головного и спинного мозга Высшая нервная деятельность. Связь
организма с внешней средой. Центры условных и безусловных
рефлексов. Нервная ткань обладает свойствами возбудимости и
проводимости
возбуждение одного нейрона на другой, устанавливая связь между
всеми органами тела
Нервные волокна – аксоны (нейриты) – длинные выросты
нейронов до 1,5 м длины. В органах заканчиваются ветвистыми
нервными окончаниями
Нервы периферической нервной системы, которые
иннервируют все органы тела Проводящие пути нервной системы.
Передают возбуждение от нервной клетки к периферии по
центробежным нейронам; от рецепторов (иннервируемых органов) – к
нервной клетке по центростремительным нейронам.
Вставочные нейроны передают возбуждение с центростремительных
(чувствительных) нейронов на центробежные(двигательные)
45.
Нервные клеткикоры
1
2
Миелиновые волокна периферического нерва в
продольном (1) и поперечном (2) срезах
46. Клетка – наименьшая обособленная частичка организма с ядром внутри.
47.
48.
КЛЕТКИ РАЗЛИЧНЫХ ТКАНЕЙ:1. Три типа нервных клеток.
2. Клетка гладкой мышечной
ткани.
3. Красная кровяная клетка
в поперечном разрезе и сбоку.
4.
Клетки
ресничного
эпителия.
49. Органеллы – постоянно присутствующие, специализированные структурные элементы цитоплазмы. Благодаря им поддерживается важнейшая
функциональная и структурнаяспециализация клетки
50.
51.
Основные проявления жизниреактивность
размножение
обмен веществ и энергии
52. 1. Реактивность (раздражимость) – свойство живой материи не только воспринимать раздражения, исходящие из внешней или
внутренней среды, но и отвечать наэти раздражения соответствующей
реакцией. Осуществляется нервной
системой, эндокринной и органами
чувств.
53. 2. Обмен веществ и энергии. Осуществляется за счёт системы пищеварения и дыхания при активном участии сердечнососудистой
системы,которая транспортирует от органов пищеварения
и дыхания ко всем органам и тканям питательные
вещества и кислород, а забирает от них продукты
метаболизма к органам выделения.
Теплорегуляция осуществляется мышечной
системой, работой различных органов и кожей.
Регуляция и адаптивная перестройка
интенсивности обменных процессов происходят
под контролем нервной системы через посредство
желез внутренней секреции и сердечнососудистой
системы.
54. 3. Размножение обеспечивает преемственность жизни на нашей планете и сохранение определенной численности видов. При ослаблении
этой способностиили с ее прекращением виды обречены на вымирание.
Для позвоночных свойственно половое размножение.
Половые клетки, вырабатываемые в половых железах,
содержат в себе всю необходимую генетическую
информацию, передаваемую будущему потомству при
оплодотворении. Осуществляется, за счет половой
системы. Процесс размножения находится под
воздействием нервной и гуморальной регуляции
55.
Общие принципы строения организмамлекопитающих
Одноосность
(биполярность)
Антимерия
(двусторонняя,
билатеральная
симметрия)
Трехслойное
строение зародыша
сегментарность
Закон
трубкообразного
строения
Расположение
непарных
органов вдоль
основной оси
тела
56.
1.2.
3.
4.
5.
6.
Одноосность (биполярность) – это наличие двух
полюсов тела: головного (краниального) и хвостового
(каудального).
Трехслойное строение зародыша – зародыш
состоит из трех слоев: энтодермы, эктодермы, мезодермы.
Антимерия (двусторонняя, билатеральная
симметрия) – выражается в сходстве по строению
правой и левой половин тела, поэтому большинство органов
парные (глаза, уши, легкие, почки, грудные и тазовые
конечности).
Сегментарность (метамерия) – близлежащие
участки тела (сегменты) близки по строению. У
млекопитающих сегментарность четко выражена в осевом
скелете.
Закон трубкообразного строения. Все системы и
аппараты организма развиваются из трубок в виде трубок
(нервная система, пищеварительный аппарат)
Расположение непарных органов вдоль
основной оси тела животного располагаются непарные
органы (сердце, печень, поджелудочная железа, трахея
57. В теле животного проводят 3 плоскости: саггитальную, сегментальную и фронтальную.
Саггитальная плоскость (серединная) – lamina saggitalis (medialis) -этоплоскость, проведённая вертикально вдоль тела животного, разделив
тело на 2 половины правую и левую. С этой плоскостью связаны 2
направления : латеральное (lateralis)и медиальное (medialis)
направления.
Сегментальная плоскость – lamina segmentalis – это плоскость,
проведённая вертикально поперёк тела, и делящая его на переднюю и
заднюю части. С этой плоскостью связаны 2 направления: краниальное
( "cranium" – голова) и каудальное ( "caudae" – хвост). В области головы
с этой плоскостью связаны направления: назальное – nasalis – к носу,
оральное (ростральное у свиней) – oralis (rostralis) – ко рту, аборальное
– aboralis – назад.
Фронтальная плоскость – lamina frontalis – это плоскость, проведённая
горизонтально поперёк тела животного, и делящая его на верхнюю и
нижнюю части. Связаны направления: дорсальное ( "dorsum" – спина) и
вентральное ( "Venter" – живот). В области конечностей: проксимальное
– proximalis – вверх, дистальное – distalis – вниз; на кисти: дорсальное –
dorsalis – вперёд, пальмарное, волярное – palmaris, volaris – назад; на
стопе: плантарное plantaris – назад, дорсальное – вперёд.
58.
59.
Основные законы биологического развитияЗакон исторического развития
Закон единства организма и среды
Закон целостности и неделимости организма
Закон единства формы и функции
Закон наследственности и изменчивости
Закон гомологичных рядов
Закон экономии материала и места
Основной биогенетический закон (Мюллера-Геккеля)
60. 1). Закон исторического развития. Филогенез – историческое развитие вида от одноклеточных до ныне существующих форм
1). Закон историческогоразвития.
Филогенез – историческое
развитие вида от одноклеточных
до ныне существующих форм
61. Принципы филогенеза по И.И. Шмальгаузену:
1. В процессе развития организма постоянно идет дифференцировкаклеток и тканей с одновременной их интеграцией. Дифференциация
– это разделение между клетками функций, одни участвуют в
переваривании пищи, другие, как например, эритроциты, в
переносе кислорода. Интеграция – это процесс укрепления между
клетками, тканями взаимосвязей, которые обеспечивают организму
целостность.
2. Каждый орган имеет несколько функций, но одна из них является
главной. Остальные функции являются как бы второстепенными,
запасными, но благодаря им, орган имеет возможность
преобразовываться.
3. При изменении условий жизни может произойти смена главной
функции на второстепенную и наоборот.
4. В организме всегда наблюдаются два противоположных процесса:
прогрессивное развитие и регрессивное (редукция). Органы,
которые утрачивают свои функции, как правило, подвергаются
редукции, т.е. постепенному исчезновению. Иногда они
сохраняются в виде рудимента (при сохранении второстепенной
функции).
5. Все изменения в организме происходят коррелятивно, т.е.
изменения в одних органах непременно ведут к изменениям в
других органах.
62.
Эритроциты и лейкоцит63.
64.
65.
Топография тимуса (грудино-щитовидные мышцы удалены). Коза, самка 8 мес.:1 – правая шейная доля; 2 – левая шейная доля; 3 – грудинная доля; 4 – отростки шейных долей; 5 – трахея
66.
67.
2). Закон единства организма исреды. Организм без внешней
среды, поддерживающей его
существование, невозможен.
68. Биологический прогресс у животных в окружающей среде по А.Н. Северцову
достигается 4 путями:а) путем ароморфоза, т.е. морфофизиологического прогресса,
в результате которого усложняется организация животного,
и происходит общий подъем энергии жизнедеятельности;
б) путем идиоадаптации, т.е. частных полезных
приспособлений, но при этом сама организация животного
не усложняется (губки, кишечнополостные);
в) путем ценогенеза, т.е. эмбриональных приспособлений,
которые развиваются только у зародышей, а у взрослых
исчезают (лягушка);
г) путем общей дегенерации, т.е. упрощением организации и
снижением интенсивности жизнедеятельности, при этом
интенсивно развивается половая система и пассивные
органы защиты, вследствие чего так же достигается победа
в борьбе за существование (паразитические плоские и
круглые черви).
69.
3). Закон целостности инеделимости организма. Этот
закон выражается в том, что
каждый организм является единым
целым, в котором все органы и
ткани находятся в тесной
взаимосвязи.
70.
71. 4) Закон единства формы и функции. Форма и функция органа образуют единое целое.
72.
73.
Желудок собаки:1 - пилорическая
часть желудка
2 - кардиальная
часть желудка
3 - фундальная
часть желудка
4 - выход 12перстной кишки
5 - кардиальное
отверстие (вход
пищевода)
74. 5). Закон наследственности и изменчивости. В ходе возникновения и развития жизни на Земле наследственность играла важную роль,
обеспечивая закрепление достигнутыхэволюционных преобразований в генотипе. Она
неразрывно связана с изменчивостью.
Благодаря наследственности и изменчивости
стало возможным существование
разнообразных групп животных, многие из
которых еще не изучены.
75.
76. 6). Закон гомологичных рядов гласит о том, чем ближе генетические виды, тем больше они имеют сходных морфологических и
физиологических признаков.77.
Гомологичные органы уживотных и человека
78. 7). Закон экономии материала и места. Согласно этому закону каждый орган и каждая система построены так, чтобы при минимальной
затратестроительного материала они
могли бы выполнять
максимальную работу.
79.
80. 8).Основной биогенетический закон (Бэра-Геккеля) состоит в том, что индивидуальное развитие организма (онтогенез) является
коротким ибыстрым повторением (рекапитуляцией)
важнейших этапов эволюции вида
(филогенеза). Например, закладка
жаберных щелей у наземных
позвоночных.
81.
Схема расположения внутренних органов у рыб:3 – пищевод; 4 – желудок; 5 – печень; 6 – поджелудочная железа; 7 – средняя кишка; 10 – задняя кишка; 15
– почка; 16 – яичник; 19 – щитовидная железа; 22 – сердце; 23 – селезенка; 24 – ротовая полость; 25 –
жабры; 26 – плавательный пузырь; 27 – клоака; 28 – яйцевод; 29 – осевой скелет
82.
Положение кишечной трубки у зародыша:1 – полость примитивного рта; 2 – язык; 3 – глотка; 4 – пищевод; 5 – зачаток трахеи; 6 – зачаток легких; 7 – селезенка; 8 –
желудок; 9 – печень; 10 – зачаток поджелудочной железы; 11 – нисходящее колено первичной кишечной петли; 12 – отрезок
аорты; 12» – краниальная брыжеечная артерия; 13 – зачаток слепой кишки на восходящем колене первичной кишечной
петли; 14 – клоака; 15 – хвостовая кишка; 16 – урахус; 17 – желточной проток в пупочном канатике
83.
Онтогенез ("онто" – один, "генез" –развитие) – это жизненный период
животного от зиготы (слияние 2х
гамет и двух половых клеток
яйцеклетки и спермотазоида) до
смерти . Различают 2 периода:
внутриутрбный (пренатальный) и
внеутробный (постнатальный).
84.
Периоды развитияПренатальный
Постнатальный
Этапы развития
новорожденности
зародышевый
предплодный
плодный
Ранний
плодный
Поздний
плодный
молочный
неполовозрелости
половозрелости
зрелый
85. Законы индивидуального развития по Л.П. Тельцову (2008)
1 закон: индивидуальное развитие состоит из 3 периодов – эмбрионального,постнатального, зрелости. Каждый период включает несколько этапов, стадий и
критических фаз (КФ);
II закон: наследственность человека и животных реализуется по этапам развития.
На каждом этапе химический состав клеток, морфологические и физиологические
возможности тканей, органов и систем организма иные;
III закон: взаимодействие последовательных этапов протекает по принципу
акселерации или ретардации. Компенсация роста и развития прямо
пропорциональна интенсивности воздействия в следующем этапе и обратно
пропорциональна возрасту;
IV закон: КФ развития организма выявляются на стыке этапов и характеризуются
активацией генов под влиянием внешних и внутренних факторов;
V закон: продолжительность критических фаз организма зависит от глубины
перестройки в последующем этапе;
VI закон: на каждом этапе развития имеются присущие только ему биологические
ритмы;
VII закон: непрерывность развития организма обусловлена асинхронностью и
гетерехронностью составляющих его систем;
VIII закон: смена этапов онтогенеза обусловлена плавностью (имманентностью) и
провизорностью (временностью) развития дефинитивных тканей, органов и систем.
На каждом этапе функционирует новая генерация тканей, органов и систем.
86. В критические фазы развития происходят:
- смена одного этапа развития организма другим;- установка генетической программы на
следующий этап;
- подведение итогов прошедшему этапу;
- десинхронизация биологических ритмов органов
и систем организма;
- повышение чувствительности тканей, органов
и систем - организма к лекарственным
веществам и к воздействию факторов внешней
среды;
- генетические мутации в клеточных
дифферонах;
- смена функций генераций временных и
дефинитивных органов организма в онтогенезе.

biology
biology








